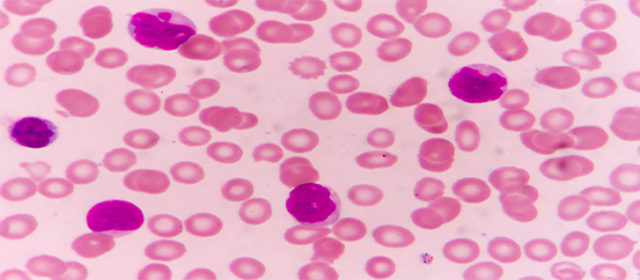

Dopo l’approvazione dell’Agenzia Italiana del Farmaco (Aifa), è ora prescrivibile in Abruzzo una nuova combinazione di farmaci, senza chemioterapia, che per la prima volta può essere prescritta per una durata fissa nei pazienti con leucemia linfatica cronica, uno dei tumori del sangue più diffusi.
“Da oggi in Abruzzo è disponibile un nuovo farmaco per la cura di pazienti con leucemia linfatica cronica, la combinazione di venetoclax e rituximab, recentemente approvato dall’Aifa – dichiara il Dott. Francesco Angrilli, Responsabile dell’UOSD Centro Diagnosi e Terapia dei Linfomi del Dipartimento Oncologico Ematologico dell’Asl di Pescara – Si tratta di una nuova classe di farmaci che è in grado di aumentare il numero di remissioni complete e il tasso di risposta complessivo nei pazienti che non hanno risposto alle terapie precedenti. A differenza delle altre terapie innovative per il trattamento della Leucemia Linfatica Cronica, questa nuova terapia, ora rimborsata dalla Regione Abruzzo, ha il vantaggio di una durata limitata e non è quindi continuativa, fino a fallimento o effetti tossici; in pratica, dopo 24 mesi i pazienti potranno interrompere l’assunzione del farmaco”.
Ogni anno in Italia circa 1.200 persone ricevono una diagnosi di Leucemia linfatica cronica, la forma di leucemia dell’adulto più frequente nel modo occidentale.[1] Si tratta di una malattia tumorale cronica del sistema linfatico che colpisce il midollo osseo, il sangue e le strutture linfatiche, caratterizzata da un’incidenza in ascesa vertiginosa nella terza età. In questi pazienti la prognosi è spesso particolarmente sfavorevole. L’ematologia italiana è fra le prime al mondo nella cura delle leucemie e linfomi con una rete di centri specializzati di eccellenza come il Centro Diagnosi e Terapia dei Linfomi dell’Asl di Pescara.
“L’ematologia è una realtà di estrema complessità oltre che di alta specializzazione – afferma il dott. Angrilli – Il Dipartimento Oncologico Ematologico dell’Asl di Pescara dispone di ematologi specializzati nella diagnosi e nelle terapie avanzate delle malattie del sangue e della leucemia linfatica cronica ed è un centro di riferimento regionale che accoglie anche pazienti di regioni limitrofe. Seguiamo presso la nostra struttura alcune centinaia di pazienti con Leucemia Linfatica Cronica, le cui nuove diagnosi sono all’incirca 40 all’anno. La nuova terapia consentirà ai pazienti che necessitano di terapia di vivere più a lungo, con la possibilità di interrompere il trattamento dopo due anni. Inoltre, la durata fissa di trattamento senza chemioterapia prevede un costo definito, con il potenziale per generare risparmi per il Sistema sanitario regionale”.